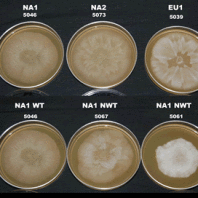
six petri dishes filled with a pale orange nutrient agar in two rows. each is labeled above with a number and an alphanumeric code. in the center of each dish, a small round sample of phytophthora was placed. Outward from each sample has grown a unique pattern of mycelia, some of which can be seen on top of the agar and some only growing within it.

WSU Research Facility
Since 2003, the WSU Puyallup Ornamental Plant Pathology Program has conducted research on Phytophthora ramorum related to host range, epidemiology, and evaluating potential control options.
In response to industry concerns, WSU built a quarter-million-dollar biocontainment facility at Puyallup. This facility has increased the capacity of WSU to address critical research questions related to the establishment, host susceptibility, spread and management of P. ramorum. A molecular lab has also been established to enhance research relating to the detection, spread, and genetics of this pathogen.

Research





Phytophthora ramorum poses substantial challenges to industries and land managers in the Western United States, including Washington State. Therefore, much of our research is dedicated to providing guidance and solutions in terms of risk assessment and management.
Below we provide information about our research in four broad categories. Click on the images or links below to find more information about the research we have conducted in each category.

Research Reports and Publications
General
- An Overview of Phytophthora ramorum in Washington State (PDF) Gary A. Chastagner, Katie Coats, and Marianne ElliottIn Frankel, S.J.; Kliejunas, J.T.; Palmieri, K.M.; Alexander, J.M. tech. coords. 2013. Proceedings of the Sudden Oak Death Fifth Science Symposium. Gen. Tech. Rep. PSW-GTR-243. Albany, CA: U.S. Department of Agriculture, Forest Service, Pacific Southwest Research Station. 169 p.
Management
- Elliott, M. and Chastagner, G. 2019. A Technique for Treating Contaminated Soil with Steam for Eradication of Phytophthora. Poster presented at the 7th Sudden Oak Death Science Symposium June 25-27 2019 San Francisco, CA.
- Biological control of tanoak resprouts using the fungus Chondrostereum purpureum. Marianne Elliott, Simon Shamoun, Grace Sumampong, Ellen Goheen, Alan Kanaskie, and Gary Chastagner. Poster presented at 59th WIFDWC, October 2011.
Nursery Management
- Gary A. Chastagner, Annie DeBauw, Kathy Riley, and Norm Dart. Effectiveness of fungicides in protecting conifers and rhododendrons from Phytophthora ramorum
- Chastagner, G.A., E.M. Hansen, K.L. Riley, and W. Sutton. 2005. Effectiveness of fungicides in protecting Douglas-fir shoots from infection by Phytophthora ramorum. Sudden Oak Death Science Symposium II, 18-21 January 2005, Monterey, CA.
- Chastagner, G.A., E.M. Hansen, K.L. Riley, and W. Sutton. 2004. Effectiveness of fungicides in protecting Douglas-fir shoots from infection by Phytophthora ramorum. Phytopathology 94: S16.
- Chastagner, G.A., E.M. Hansen. 2003. Identification of fungicides to control sudden oak death. Christmas Tree Lookout 36(3): 7-9.
- Chastagner, G.A., E.M. Hansen, K.L. Riley, and W. Sutton. 2003. Identification of fungicides to control sudden oak death. In: Program and abstract book, sixth international Christmas tree research and extension conference; 2003 Sept. 14-19; Hendersonville, NC; 36.
- Influence of Nitrogen Fertility on the Susceptibility of Rhododendrons to Phytophthora ramorum in Proceedings of the Sudden Oak Death Fourth Science Symposium (PDF) 2010. Susan J. Frankel, John T. Kliejunas, and Katharine M. Palmieri, tech. coords. Gen. Tech. Rep. PSW-GTR-229. Albany, CA: U.S. Department of Agriculture, Forest Service, Pacific Southwest Research Station. 378.
Host Susceptibility
- Susceptibility of Larch, Hemlock, Sitka Spruce, and Douglas-fir to Phytophthora ramorum Gary Chastagner, Kathy Riley, and Marianne Elliott. In Frankel, S.J.; Kliejunas, J.T.; Palmieri, K.M.; Alexander, J.M. tech. coords. 2013. Proceedings of the Sudden Oak Death Fifth Science Symposium. Gen. Tech. Rep. PSW-GTR-243. Albany, CA: U.S. Department of Agriculture, Forest Service, Pacific Southwest Research Station. 169 p.
- Symptoms Associated with Inoculation of Stems on Living Douglas-fir and Grand Fir Trees with Phytophthora ramorum Gary Chastagner, Kathy Riley, Katie Coats, Marianne Elliott, Annie DeBauw, and Norm Dart. In Frankel, Susan J.; Kliejunas, John T.; Palmieri, Katharine M. 2010. Proceedings of the Sudden Oak Death Fourth Science Symposium. Gen. Tech. Rep. PSW-GTR-229. Albany, CA: U.S. Department of Agriculture, Forest Service, Pacific Southwest Research Station. 378 p.
- Chastagner, G.A., E.M. Hansen, K.L. Riley, and W. Sutton. 2005. Susceptibility of conifer shoots to infection by Phytophthora ramorum. Sudden Oak Death Science Symposium II, 18-21 January 2005, Monterey, CA.
- Chastagner, G.A., E.M. Hansen, K.L. Riley, and W. Sutton. 2004. Susceptibility of conifer shoots to infection by Phytophthora ramorum. Phytopathology 94: S16.
- Chastagner, G.A., K.L. Riley, E.M. Hansen, and W. Sutton. 2004. Christmas tree and conifer nursery stock: Sudden oak death project update. Christmas Tree Lookout 37(3): 10-13
- Chastagner, G.A., E.M. Hansen, K.L. Riley, and W. Sutton. 2003. Susceptibility of conifer shoots to infection by Phytophthora ramorum. In: Program and abstract book, sixth international Christmas tree research and extension conference; 2003 Sept. 14-19; Hendersonville, NC; 10-11.
- Phytophthora ramorum isolated from California bay laurel inflorescences and mistletoe: possible implications relating to disease spread Gary A. Chastagner, Kathy Riley, and Norm Dart
Biology and Spread
- Phenotypic variation in Phytophthora ramorum: wild type vs non-wild type isolates in Proceedings of the Sudden Oak Death Fourth Science Symposium 2010. Susan J. Frankel, John T. Kliejunas, and Katharine M. Palmieri, tech. coords. Gen. Tech. Rep. PSW-GTR-229. Albany, CA: U.S. Department of Agriculture, Forest Service, Pacific Southwest Research Station. 378.
- Spread of Phytophthora ramorum to water, soil, and vegetation outside a nursery in Pierce County, Washington G. Chastagner, K. Coats, M. Elliott, Phytopathology 101:S32
- Volunteer stream monitoring for invasive Phytophthora species in western Washington M. Elliot, G. Chastagner, K. P. Coats, A. DeBauw, K. Riley. Phytopathology 101:S48
- Mystery on the Sammamish: What are the sources of Phytophthora ramorum infesting this Washington State waterway? G. Chastagner, K. COATS, D. Omdal, A. Ramsey-Kroll, M. Elliott. Phytopathology 101:S32
- Determining the Risk of Phytophthora ramorum Spread From Nurseries Via Waterways Marianne Elliott, Gary Chastagner, Katie Coats, and Gil Dermott In Frankel, S.J.; Kliejunas, J.T.; Palmieri, K.M.; Alexander, J.M. tech. coords. 2013. Proceedings of the Sudden Oak Death Fifth Science Symposium. Gen. Tech. Rep. PSW-GTR-243. Albany, CA: U.S. Department of Agriculture, Forest Service, Pacific Southwest Research Station. 169 p.
- Spread of P. ramorum from Nurseries into Waterways—Implications for Pathogen Establishment in New Areas Gary Chastagner, Steven Oak, Daniel Omdal, Amy Ramsey-Kroll, Katie Coats, Yana Valachovic, Chris Lee, Jaesoon Hwang, Steven Jeffers, and Marianne Elliott. in Proceedings of the Sudden Oak Death Fourth Science Symposium (PDF) 2010. Susan J. Frankel, John T. Kliejunas, and Katharine M. Palmieri, tech. coords. Gen. Tech. Rep. PSW-GTR-229. Albany, CA: U.S. Department of Agriculture, Forest Service, Pacific Southwest Research Station. 378.
- An Update on Microsatellite Genotype Information of Phytophthora ramorum in Washington State Nurseries 14 KBKatie Coats, Gary Chastagner, Norm Dart, Meg M. Larsen, and Niklaus J. Grunwald in Proceedings of the Sudden Oak Death Fourth Science Symposium 2010. Susan J. Frankel, John T. Kliejunas, and Katharine M. Palmieri, tech. coords. Gen. Tech. Rep. PSW-GTR-229. Albany, CA: U.S. Department of Agriculture, Forest Service, Pacific Southwest Research Station. 378.
WSU Puyallup Research & Extension Center
2606 West Pioneer, Puyallup, WA, 98371-4998 USA
Last updated 9/25/2025